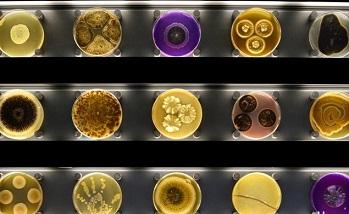
بانک ژن گیاهی و میکروارگانیسم ها

بانک ژن گیاهی و میکروارگانیسم ها
خدمت
کاربردها و مصارف: تولید نمونه گیاهی و میکرو ارگانیسم ها
نام واحد: مرکز ملی ذخائر
نحوه تماس و ثبت سفارش: مرکز ملی ذخائر
مصرف کنندگان: دانشگاه ها و مرا کز پژ<هشی
کارفرما:دانشگاه و مرا کز پژوهش
گروه های استفاده کنندگان(گیرندگان خدمات):دانشگاه و مرا کز پژوهش
اطلاعات هماهنگ کننده: مرکز ملی ذخائر
دستاوردهای بانک ژن گیاهی مرکز ملی دخایر ژنتیکی و زیستی ایران
- نگه داری 1100 نمونه زنده از گیاهان پیازی و ریزوم دار
- نگه 10300 نمونه بذری در سردخانه های بانک و در شرایط استاندارد
- جمع آوری و شناسنامه دار کرده 8700 شیت هرباریومی
- تولید بذور هیبریدی
ارسال نظر برای این محصول مجاز نیست.



